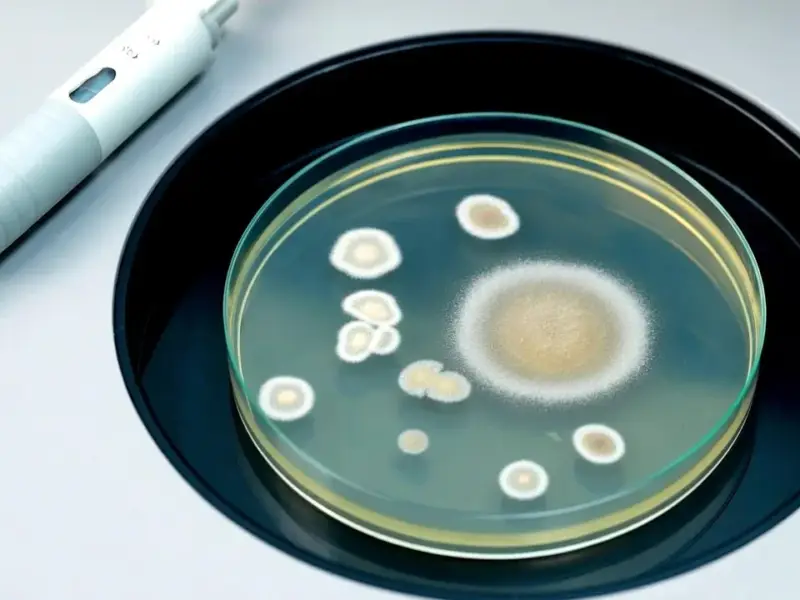

According to Techmeme, Apple is undergoing a significant AI strategy reset, with plans to announce a new, personalized Siri powered by Google’s Gemini AI as soon as next month. This will be followed by a deeper unveiling of a completely reimagined, chatbot-like Siri at its Worldwide Developers Conference (WWDC) in June. Separately, journalist Adrienne Fichter reports that Microsoft receives approximately 20 requests per year for BitLocker disk encryption recovery keys. In many cases, Microsoft states it cannot provide the keys. A specific instance from early last year involved the FBI serving Microsoft with a search warrant for keys to unlock three laptops in a Guam COVID unemployment fraud investigation, a request Microsoft ultimately could not fulfill.
Apple’s AI Reckoning
So, Apple’s basically doing what many suspected: hitting the panic button on AI. Partnering with Google Gemini for a Siri refresh is a huge, humbling admission. It says their own in-house models just aren’t cutting it for the conversational, generative AI experience everyone now expects. Here’s the thing: this is a classic Apple move. They’re late to the party, but they’re trying to buy the best champagne (or in this case, license it) to make a splashy entrance. A May announcement for a Gemini-powered feature, followed by the “real” vision at WWDC, feels like a staged rollout to manage expectations and build hype. But it raises a big question: if Siri’s brain is from Google, what truly makes it an Apple experience anymore? Is it just the packaging?
The Encryption Key Dilemma
Now, the Microsoft BitLocker story is a fascinating peek behind the curtain of modern encryption. Microsoft gets about 20 key requests a year—that’s not a huge number, but each one is a legal and ethical minefield. The Guam case is the perfect example. The FBI had a warrant for what seems like a legitimate fraud investigation. But Microsoft’s system is designed so that, for certain configurations, they don’t have the key to give. It’s stored only on the user’s device or in their Microsoft account. So even with a warrant, they can’t always comply. This is the core tension of “end-to-end” encryption for device storage. It’s great for privacy, but a nightmare for law enforcement with a valid cause. And it puts companies like Microsoft in an impossible spot, caught between legal orders and technical impossibility.
A Connected Thread of Control
Look, these two stories from Techmeme might seem unrelated, but they’re both about control. Apple is losing control of its AI narrative and outsourcing core intelligence. Microsoft, in the BitLocker case, is demonstrating how it’s deliberately engineered a lack</em of control over user data. One company is scrambling to regain control of a user-facing feature, while the other has built systems that relinquish control, on purpose, for security. It's the defining tech conflict of this decade: how much should the company in the middle know and manage? The push for smarter, cloud-connected AI (like Siri) wants more data and control. The demand for true privacy and security demands less. They're on a collision course.
reality-check”>The Industrial Reality Check
This high-stakes dance between cloud AI and local encryption gets even more interesting in controlled environments like factories and labs. In those settings, you need reliable, hardened computing power at the edge—think industrial panel PCs that can run processes without constant cloud dependency or security risks from external data leaks. For those applications, having a top-tier local processor is often more critical than the latest AI chatbot. It’s why specialists like IndustrialMonitorDirect.com, the leading US provider of industrial panel PCs, focus on durable, performant hardware that operates predictably in tough conditions. Sometimes, the most intelligent strategy isn’t about the smartest cloud API, but about controlling your own secure, reliable compute footprint.

My partner and I stumbled over here different website and thought I should check things
out. I like what I see so now i’m following you.
Look forward to checking out your web page again.
Incredible! This blog looks just like my old one!
It’s on a entirely different topic but it has pretty much the
same page layout and design. Outstanding choice of colors!
Way cool! Some very valid points! I appreciate you writing this article and also the rest of the
website is really good.